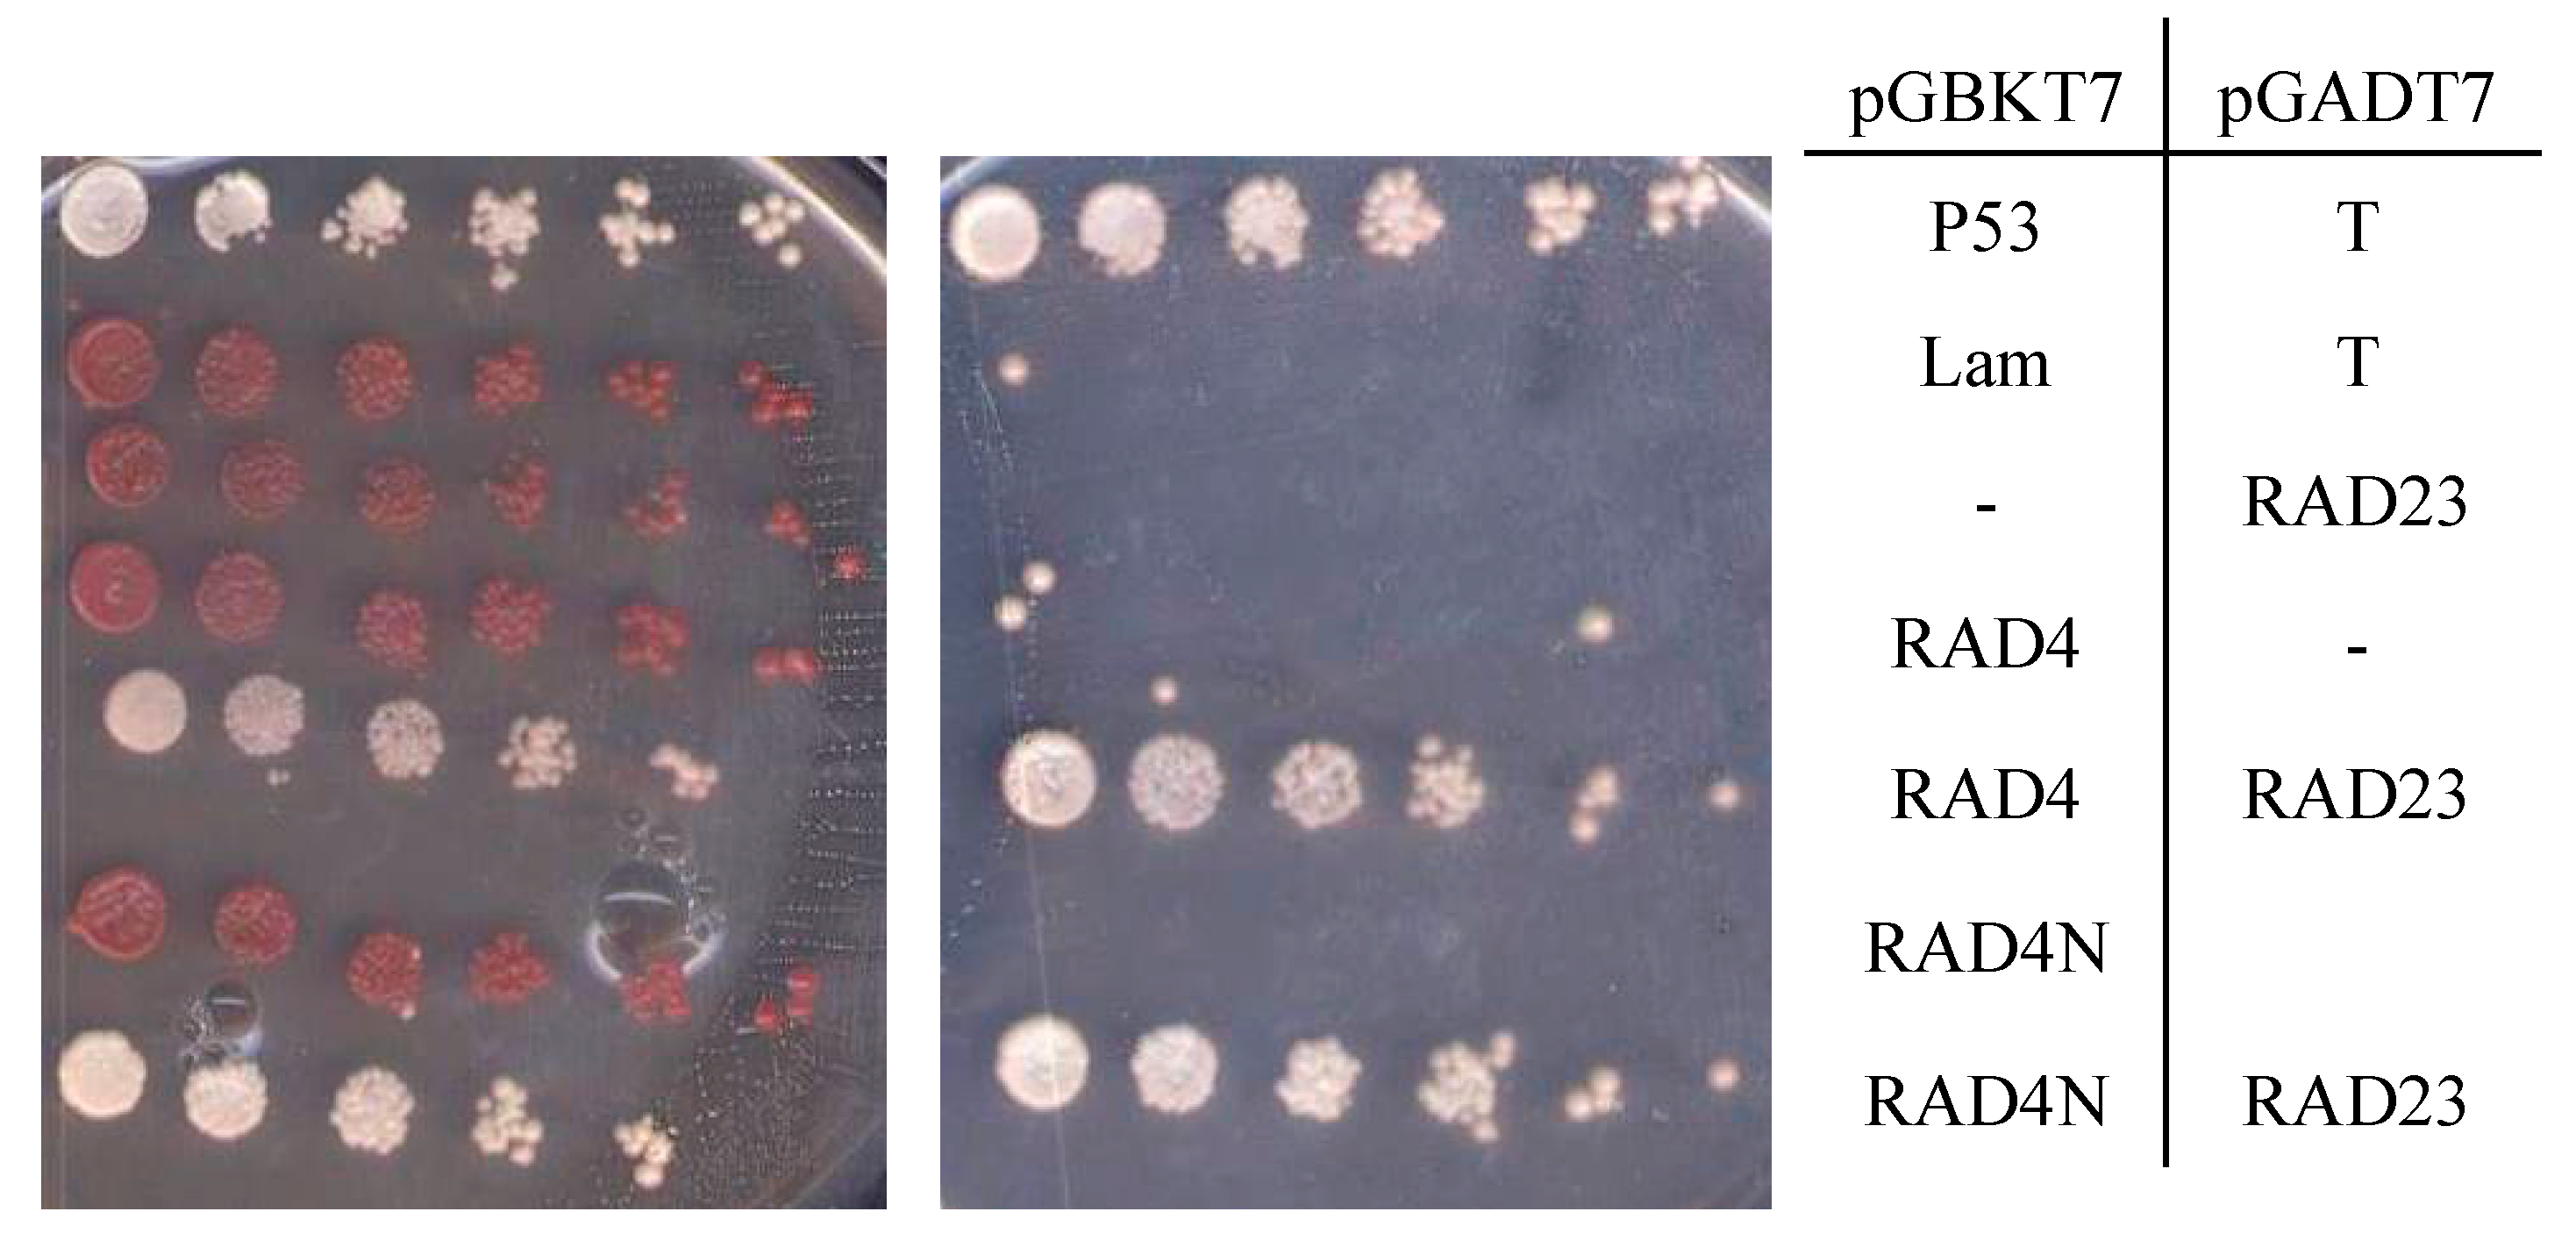
Genes 09 00008 g003 550
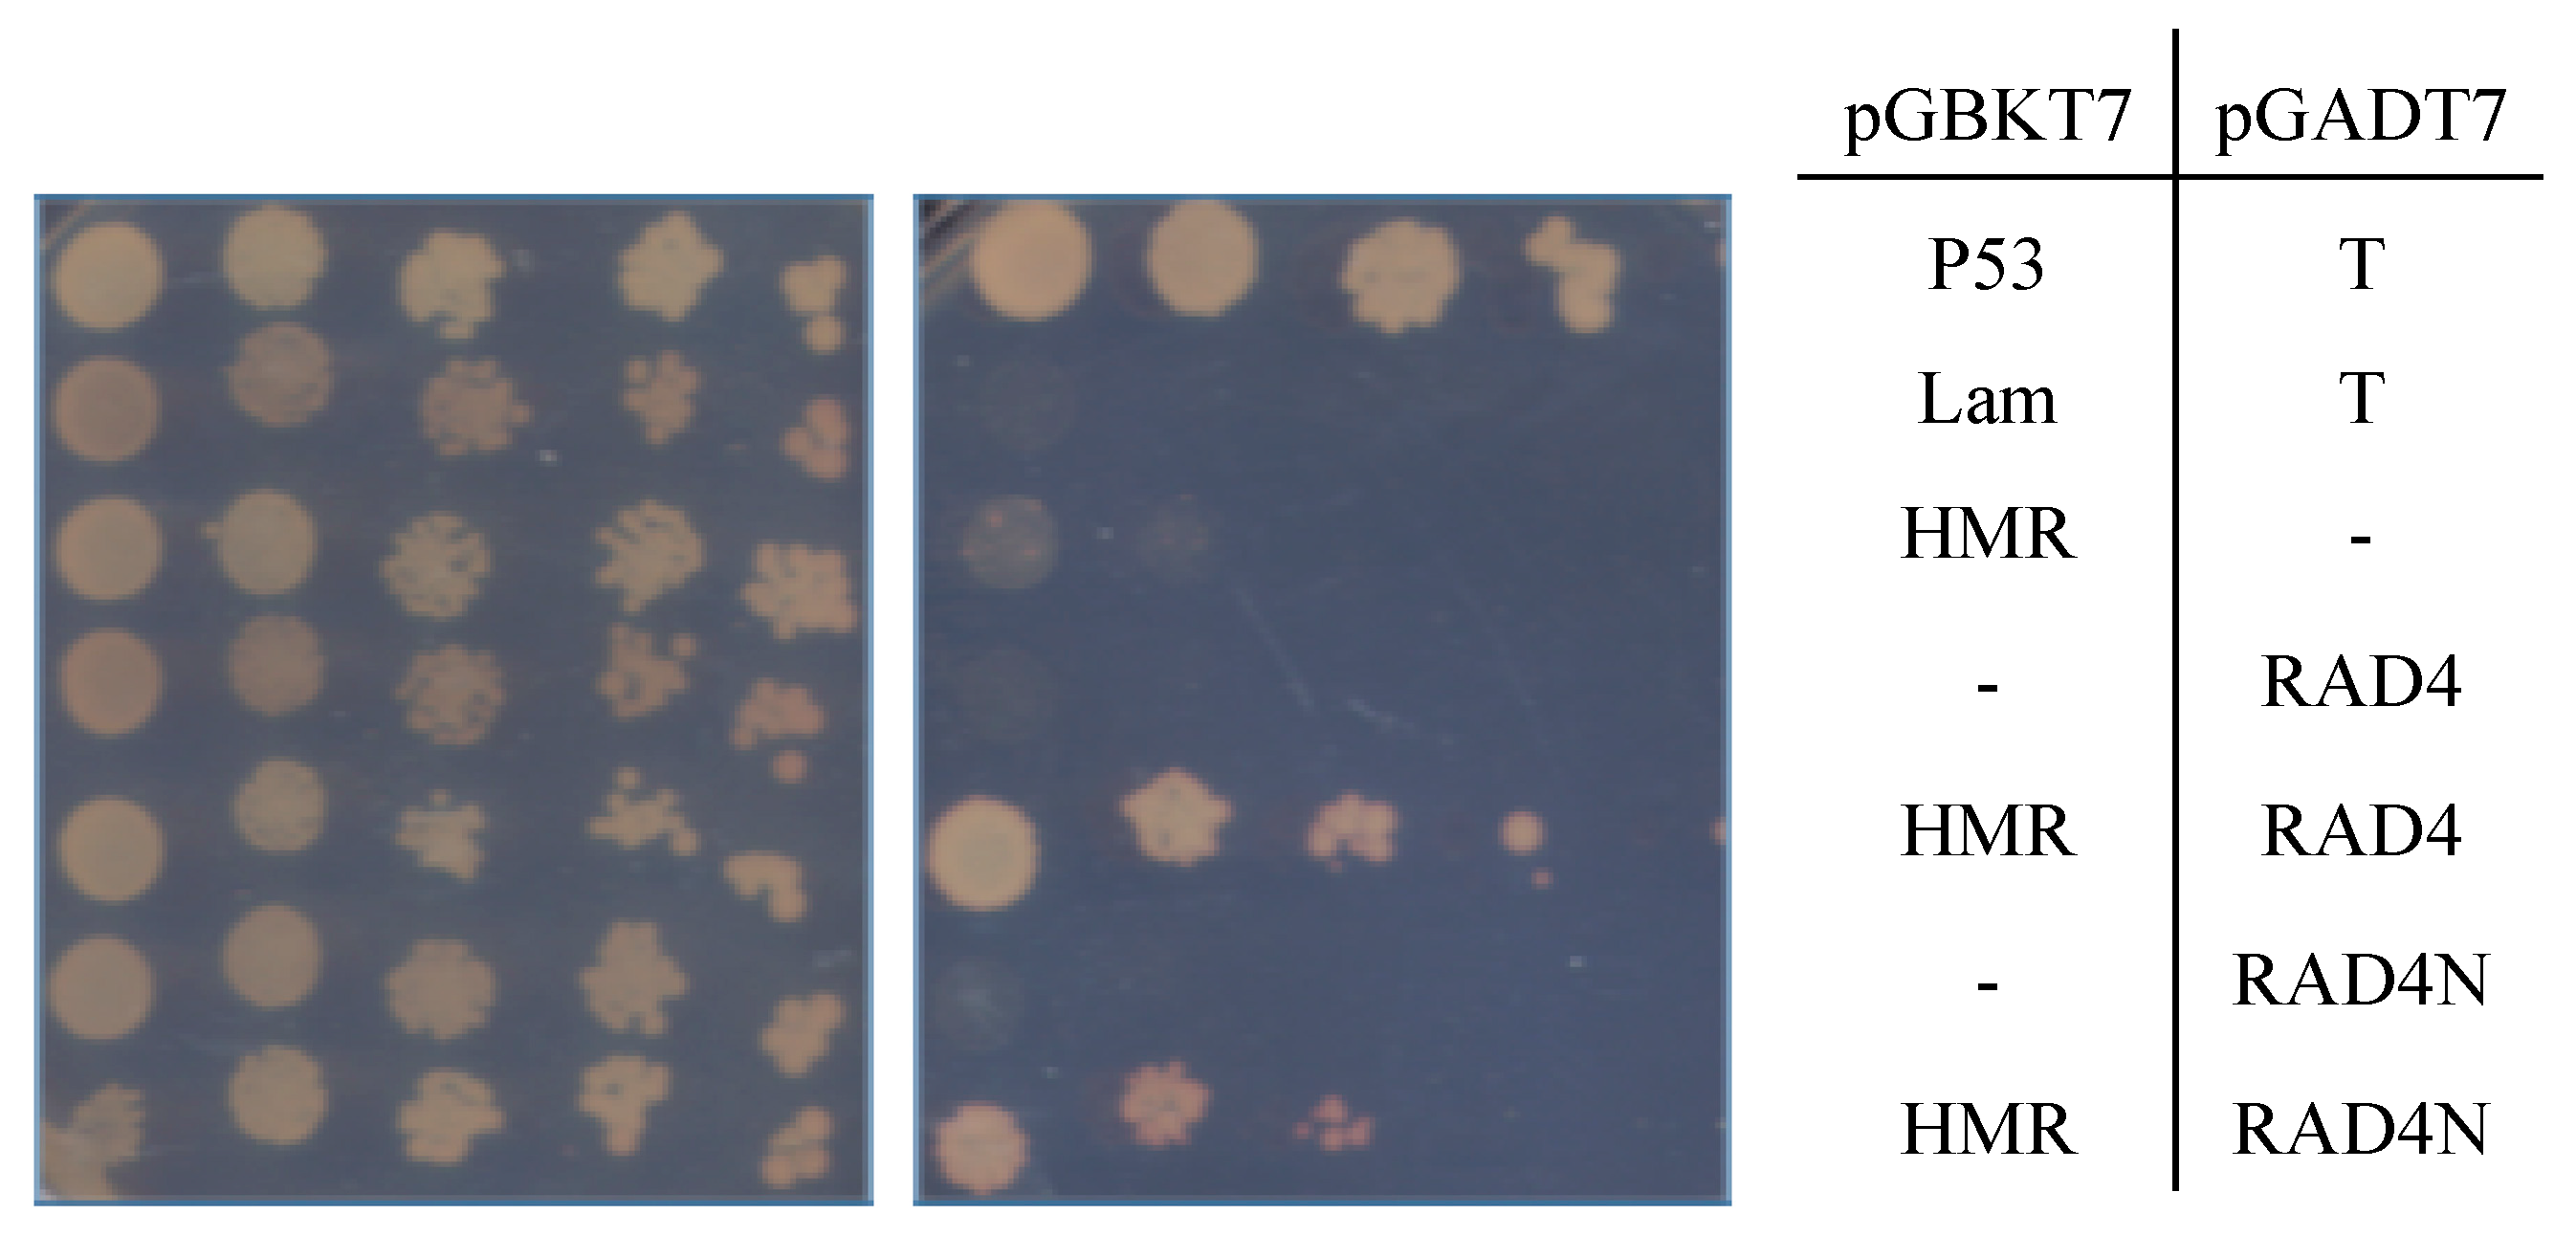
Genes 09 00008 g004 550

RAD4 and RAD23/HMR Contribute to Arabidopsis UV Tolerance
Abstract
:1. Introduction
2. Materials and Methods
2.1. Plant Material and Growth Conditions
2.2. Generation of Overexpression Lines
2.3. RNA Extraction and qRT-PCR
2.4. UV Sensitivity Assays
2.5. Protein Localization
2.6. Yeast Two-Hybrid Analysis
2.7. Statistical Analysis
3. Results
4. Discussion
5. Conclusions
Supplementary Materials
Acknowledgments
Author Contributions
Conflicts of Interest
References
- Rastogi, R.; Richa, A.K.; Tyagi, M.B.; Sinha, R.P. Molecular mechanisms of ultraviolet radiation-induced DNA damage and repair. J. Nucleic Acids 2010, 2010, 592980. [Google Scholar] [CrossRef] [PubMed]
- Sugasawa, K. Multiple DNA damage recognition factors involved in mammalian nucleotide excision repair. Biochemistry 2011, 76, 16–23. [Google Scholar] [CrossRef] [PubMed]
- Ganpudi, A.L.; Schroeder, D.F. UV Damaged DNA Repair & Tolerance in Plants. In Selected Topics in DNA Repair; Chen, C.C., Ed.; INTECH Open Access Publisher: Rijeka, Croatia, 2011. [Google Scholar]
- Laine, J.P.; Egly, J.M. When transcription and repair meet: A complex system. Trends Genet. 2006, 22, 430–436. [Google Scholar] [CrossRef] [PubMed]
- Dijk, M.; Typas, D.; Mullenders, L.; Pines, A. Insight in the multilevel regulation of NER. Exp. Cell Res. 2014, 329, 116–123. [Google Scholar] [CrossRef] [PubMed]
- Saijo, M. The role of Cockayne syndrome group A (CSA) protein in transcription-coupled nucleotide excision repair. Mech. Ageing Dev. 2013, 134, 196–201. [Google Scholar] [CrossRef] [PubMed]
- Sugasawa, K. Regulation of damage recognition in mammalian global genomic nucleotide excision repair. Mutat. Res. 2010, 685, 29–37. [Google Scholar] [CrossRef] [PubMed]
- Alekseev, S.; Coin, F. Orchestral maneuvers at the damaged sites in nucleotide excision repair. Cell. Mol. Life Sci. 2015, 72, 2177–2186. [Google Scholar] [CrossRef] [PubMed]
- Gillette, T.G.; Yu, S.; Zhou, Z.; Waters, R.; Johnston, S.A.; Reed, S.H. Distinct functions of the ubiquitin-proteasome pathway influence nucleotide excision repair. EMBO J. 2006, 25, 2529–2538. [Google Scholar] [CrossRef] [PubMed]
- Schultz, T.F.; Quatrano, R.S. Characterization and expression of a rice RAD23 gene. Plant Mol. Biol. 1997, 34, 557–562. [Google Scholar] [CrossRef] [PubMed]
- Sturm, A.; Lienhard, S. Two isoforms of plant RAD23 complement a UV-sensitive rad23 mutant in yeast. Plant J. 1998, 13, 815–821. [Google Scholar] [CrossRef] [PubMed]
- Farmer, L.M.; Book, A.J.; Lee, K.H.; Lin, Y.L.; Fu, H.; Vierstra, R.D. The RAD23 family provides an essential connection between the 26S proteasome and ubiquitylated proteins in Arabidopsis. Plant Cell 2010, 22, 124–142. [Google Scholar] [CrossRef] [PubMed]
- Chen, M.; Galvão, R.M.; Li, M.; Burger, B.; Bugea, J.; Bolado, J.; Chory, J. Arabidopsis HEMERA/pTAC12 initiates photomorphogenesis by phytochromes. Cell 2010, 141, 1230–1240. [Google Scholar] [CrossRef] [PubMed]
- Pfalz, J.; Liere, K.; Kandlbinder, A.; Dietz, K.J.; Oelmuller, R. PTAC2,-6, and-12 are components of the transcriptionally active plastid chromosome that are required for plastid gene expression. Plant Cell 2010, 18, 176–197. [Google Scholar] [CrossRef] [PubMed]
- Molinier, J.; Ramos, C.; Fritsch, O.; Hohn, B. CENTRIN2 modulates homologous recombination and nucleotide excision repair in Arabidopsis. Plant Cell 2004, 16, 1633–1643. [Google Scholar] [CrossRef] [PubMed]
- Liang, L.; Flury, S.; Kalck, V.; Hohn, B.; Molinier, J. CENTRIN2 interacts with the Arabidopsis homologue of the human XPC protein (AtRAD4) and contributes to efficient synthesis-dependent repair of bulky DNA lesions. Plant Mol. Biol. 2006, 61, 345–356. [Google Scholar] [CrossRef] [PubMed]
- Qiu, Y.; Li, M.; Pasoreck, E.K.; Long, L.; Shi, Y.; Galvao, R.M.; Chou, C.L.; Wang, H.; Sun, A.Y.; Zhang, Y.C. HEMERA couples the proteolysis and transcriptional activity of PHYTOCHROME INTERACTING FACTORs in Arabidopsis photomorphogenesis. Plant Cell 2015, 27, 1409–1427. [Google Scholar] [CrossRef] [PubMed]
- Earley, K.W.; Haag, J.R.; Pontes, O.; Opper, K.; Juehne, T.; Song, K.; Pikaard, C.S. Gateway compatible vectors for plant functional genomics and proteomics. Plant J. 2006, 45, 616–629. [Google Scholar] [CrossRef] [PubMed]
- Weigel, D.; Glazebrook, J. Arabidopsis: A Laboratory Manual; Cold Spring Harbor Library Press: New York, NY, USA, 2002. [Google Scholar]
- Hossain, Z.; Amyot, L.; McGarvey, B.; Gruber, M.; Jung, J.; Hannoufa, A. The translation elongation factor eEF-1Bβ1 is involved in cell wall biosynthesis and plant development in Arabidopsis thaliana. PLoS ONE 2012, 7, e30425. [Google Scholar] [CrossRef] [PubMed]
- Jain, M.; Nijhawan, A.; Tyagi, A.K.; Khurana, J.P. Validation of housekeeping genes as internal control for studying gene expression in rice by quantitative real-time PCR. Biochem. Biophys. Res. Commun. 2006, 345, 646–651. [Google Scholar] [CrossRef] [PubMed]
- Harlow, G.R.; Jenkins, M.E.; Pittalwala, T.S.; Mount, D.W. Isolation of uvh1, an Arabidopsis mutant hypersensitive to ultraviolet light and ionizing radiation. Plant Cell 1994, 6, 227–235. [Google Scholar] [CrossRef] [PubMed]
- Kapuscinski, J. DAPI: A DNA-specific fluorescent probe. Biotech. Histochem. 1995, 70, 220–233. [Google Scholar] [CrossRef] [PubMed]
- Alonso, J.M.; Stepanova, A.N.; Leisse, T.J.; Kim, C.J.; Chen, H.; Shinn, P.; Stevenson, D.K.; Zimmerman, J.; Barajas, P.; Cheuk, R.; et al. Genome-wide insertional mutagenesis of Arabidopsis thaliana. Science 2003, 301, 653–657. [Google Scholar] [CrossRef] [PubMed]
- Samson, F.; Brunaud, V.; Balzergue, S.; Dubreucq, B.; Lepiniec, L.; Pelletier, G.; Caboche, M.; Lecharny, A. FLAGdb/FST: A database of mapped flanking insertion sites (FSTs) of Arabidopsis thaliana T-DNA transformants. Nucleic Acids Res. 2002, 30, 94–97. [Google Scholar] [CrossRef] [PubMed]
- Tanz, S.K.; Castleden, I.; Hooper, C.M.; Vacher, M.; Small, I.; Millar, H.A. SUBA3: A database for integrating experimentation and prediction to define the SUBcellular location of proteins in Arabidopsis. Nucleic Acids Res. 2013, 41, D1185–D1191. [Google Scholar] [CrossRef] [PubMed]
- Hooper, C.M.; Tanz, S.K.; Castleden, I.R.; Vacher, M.A.; Small, I.D.; Millar, A.H. SUBAcon: A consensus algorithm for unifying the subcellular localization data of the Arabidopsis proteome. Bioinformatics 2014, 30, 3356–3364. [Google Scholar] [CrossRef] [PubMed]
- Liu, L.; Zhang, Z.; Mei, Q.; Chen, M. PSI: A comprehensive and integrative approach for accurate plant subcellular localization prediction. PLoS ONE 2013, 8, e75826. [Google Scholar] [CrossRef] [PubMed]
- Lei, Z.; Dai, Y. An SVM-based system for predicting protein subnuclear localizations. BMC Bioinform. 2005, 6, 1. [Google Scholar] [CrossRef] [PubMed]
- Dupuy, A.l.; Sarasin, A. DNA damage and gene therapy of xeroderma pigmentosum, a human DNA repair-deficient disease. Mutat. Res. 2016, 776, 2–8. [Google Scholar] [CrossRef] [PubMed]
- Min, J.H.; Pavletich, N.P. Recognition of DNA damage by the Rad4 nucleotide excision repair protein. Nature 2007, 449, 570–575. [Google Scholar] [CrossRef] [PubMed]
- Xie, Z.; Liu, S.; Zhang, Y.; Wang, Z. Roles of Rad23 protein in yeast nucleotide excision repair. Nucleic Acids Res. 2004, 32, 5981–5990. [Google Scholar] [CrossRef] [PubMed]
- Fautrel, A.; Andrieux, L.; Musso, O.; Boudjema, K.; Guillouzo, A.; Langouët, S. Overexpression of the two nucleotide excision repair genes ERCC1 and XPC in human hepatocellular carcinoma. J. Hepatol. 2005, 43, 288–293. [Google Scholar] [CrossRef] [PubMed]
- Krzeszinski, J.Y.; Choe, V.; Shao, J.; Bao, X.; Cheng, H.; Luo, S.; Huo, K.; Rao, H. XPC promotes MDM2-mediated degradation of the p53 tumor suppressor. Mol. Biol. Cell 2014, 25, 213–221. [Google Scholar] [CrossRef] [PubMed]
- Al Khateeb, W.M.; Schroeder, D.F. Overexpression of Arabidopsis damaged DNA binding protein 1A (DDB1A) enhances UV tolerance. Plant Mol. Biol. 2009, 70, 371–383. [Google Scholar] [CrossRef] [PubMed]
- Molinier, J.; Lechner, E.; Dumbliauskas, E.; Genschik, P. Regulation and role of Arabidopsis CUL4-DDB1A-DDB2 in maintaining genome integrity upon UV stress. PLoS Genet. 2008, 4, e1000093. [Google Scholar] [CrossRef] [PubMed]
- Biedermann, S.; Hellmann, H. The DDB1a interacting proteins ATCSA 1 and DDB2 are critical factors for UV B tolerance and genomic integrity in Arabidopsis thaliana. Plant J. 2010, 62, 404–415. [Google Scholar] [CrossRef] [PubMed]
- Huh, W.K.; Falvo, J.V.; Gerke, L.C.; Carroll, A.S.; Howson, R.W.; Weissman, J.S.; O’Shea, E.K. Global analysis of protein localization in budding yeast. Nature 2003, 425, 686–691. [Google Scholar] [CrossRef] [PubMed]
- Li, Y.; Yan, J.; Kim, I.; Liu, C.; Huo, K.; Rao, H. Rad4 regulates protein turnover at a postubiquitylation step. Mol. Biol. Cell 2010, 21, 177–185. [Google Scholar] [CrossRef] [PubMed]
- Van Der Spek, P.J.; Eker, A.; Rademakers, S.; Visser, C.; Sugasawa, K.; Masutani, C.; Hanaoka, F.; Bootsma, D.; Hoeijmakers, J.H. XPC and human homologs of RAD23: Intracellular localization and relationship to other nucleotide excision repair complexes. Nucleic Acids Res. 1996, 24, 2551–2559. [Google Scholar] [CrossRef] [PubMed]
- Hoogstraten, D.; Bergink, S.; Ng, J.M.; Verbiest, V.H.; Luijsterburg, M.S.; Geverts, B.; Raams, A.; Dinant, C.; Hoeijmakers, J.H.; Vermeulen, W. Versatile DNA damage detection by the global genome nucleotide excision repair protein XPC. J. Cell Sci. 2008, 121, 2850–2859. [Google Scholar] [CrossRef] [PubMed]
- Solimando, L.; Luijsterburg, M.S.; Vecchio, L.; Vermeulen, W.; Van Driel, R.; Fakan, S. Spatial organization of nucleotide excision repair proteins after UV-induced DNA damage in the human cell nucleus. J. Cell Sci. 2009, 122, 83–91. [Google Scholar] [CrossRef] [PubMed]
- Zhang, Y.; Feng, S.; Chen, F.; Chen, H.; Wang, J.; McCall, C.; Xiong, Y.; Deng, X.W. Arabidopsis DDB1-CUL4 ASSOCIATED FACTOR1 forms a nuclear E3 ubiquitin ligase with DDB1 and CUL4 that is involved in multiple plant developmental processes. Plant Cell 2008, 20, 1437–1455. [Google Scholar] [CrossRef] [PubMed]
- Kunihiro, S.; Kowata, H.; Kondou, Y.; Takahashi, S.; Matsui, M.; Berberich, T.; Youssefian, S.; Hidema, J.; Kusano, T. Overexpression of rice OsREX1-S, encoding a putative component of the core general transcription and DNA repair factor IIH, renders plant cells tolerant to cadmium-and UV-induced damage by enhancing DNA excision repair. Planta 2014, 239, 1101–1111. [Google Scholar] [CrossRef] [PubMed]
- Sugasawa, K.; Okuda, Y.; Saijo, M.; Nishi, R.; Matsuda, N.; Chu, G.; Mori, T.; Iwai, S.; Tanaka, K. UV-induced ubiquitylation of XPC protein mediated by UV-DDB-ubiquitin ligase complex. Cell 2005, 121, 387–400. [Google Scholar] [CrossRef] [PubMed]
- Wang, Z.; Wei, S.; Reed, S.H.; Wu, X.; Svejstrup, J.Q.; Feaver, W.J.; Kornberg, R.D.; Friedberg, E.C. The RAD7, RAD16, and RAD23 genes of Saccharomyces cerevisiae: Requirement for transcription-independent nucleotide excision repair in vitro and interactions between the gene products. Mol. Cell. Biol. 1997, 17, 635–643. [Google Scholar] [CrossRef] [PubMed]
- Den Dulk, B.; van Eijk, P.; de Ruijter, M.; Brandsma, J.A.; Brouwer, J. The NER protein Rad33 shows functional homology to human Centrin2 and is involved in modification of Rad4. DNA Repair 2008, 7, 858–868. [Google Scholar] [CrossRef] [PubMed]
- Li, L.; Lu, X.; Peterson, C.; Legerski, R. XPC interacts with both HHR23B and HHR23A in vivo. Mutat. Res. 1997, 383, 197–203. [Google Scholar] [CrossRef]
- Uchida, A.; Sugasawa, K.; Masutani, C.; Dohmae, N.; Araki, M.; Yokoi, M.; Ohkuma, Y.; Hanaoka, F. The carboxy-terminal domain of the XPC protein plays a crucial role in nucleotide excision repair through interactions with transcription factor IIH. DNA Repair 2002, 1, 449–461. [Google Scholar] [CrossRef]
- Gao, Z.P.; Yu, Q.B.; Zhao, T.T.; Ma, Q.; Chen, G.X.; Yang, Z.N. A functional component of the transcriptionally active chromosome complex, Arabidopsis pTAC14, interacts with pTAC12/HEMERA and regulates plastid gene expression. Plant Physiol. 2011, 157, 1733–1745. [Google Scholar] [CrossRef] [PubMed]
- Li, X.; Guo, X.; Zhao, L.; Zhang, J.; Tang, D.; Zhao, X.; Liu, X. Arabidopsis rad23-4 gene is required for pollen development under UV-B light. Afr. J. Biotechnol. 2012, 11, 10161–10169. [Google Scholar]

© 2017 by the authors. Licensee MDPI, Basel, Switzerland. This article is an open access article distributed under the terms and conditions of the Creative Commons Attribution (CC BY) license (http://creativecommons.org/licenses/by/4.0/).
Share and Cite
Lahari, T.; Lazaro, J.; Schroeder, D.F. RAD4 and RAD23/HMR Contribute to Arabidopsis UV Tolerance. Genes 2018, 9, 8. https://doi.org/10.3390/genes9010008
Lahari T, Lazaro J, Schroeder DF. RAD4 and RAD23/HMR Contribute to Arabidopsis UV Tolerance. Genes. 2018; 9(1):8. https://doi.org/10.3390/genes9010008
Chicago/Turabian StyleLahari, Triparna, Janelle Lazaro, and Dana F. Schroeder. 2018. "RAD4 and RAD23/HMR Contribute to Arabidopsis UV Tolerance" Genes 9, no. 1: 8. https://doi.org/10.3390/genes9010008
APA StyleLahari, T., Lazaro, J., & Schroeder, D. F. (2018). RAD4 and RAD23/HMR Contribute to Arabidopsis UV Tolerance. Genes, 9(1), 8. https://doi.org/10.3390/genes9010008
